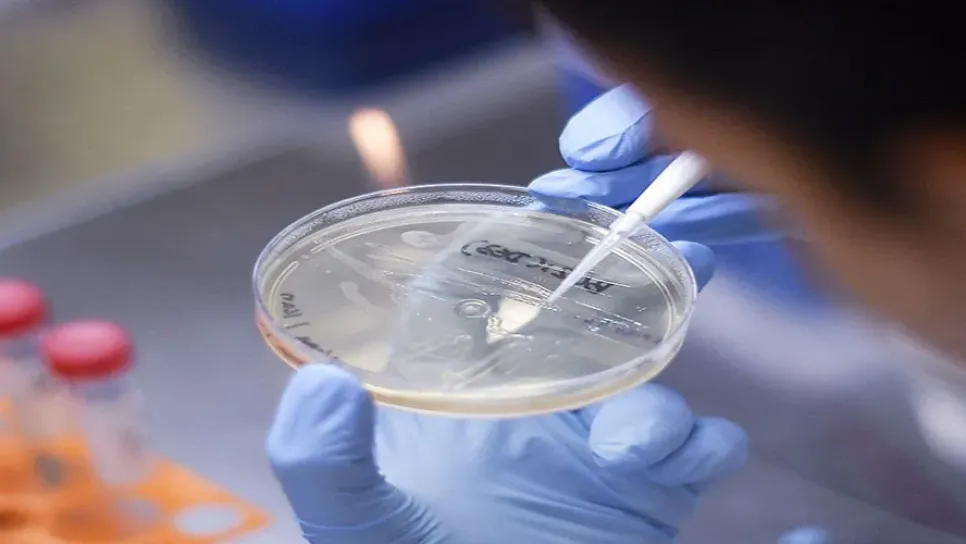

أعلن علماء بريطانيون وممثلون عن شركة الأدوية " "AstraZeneca، التي طورت لقاح ضد "كوفيد-19" تحت مسمى "AZD1222" تعليق تجاربها السريرية ليس فقط في الولايات المتحدة، ولكن أيضًا في جنوب إفريقيا والبرازيل والمملكة المتحدة بعد أن أصيب أحد المتطوعين بمضاعفات. ووفقا لمجلة "Nature"، فإن "ممثلين من جامعة أكسفورد أكدوا يوم الأربعاء أن تجنيد متطوعين للمشاركة في المرحلة الثالثة من التجارب السريرية للقاح المقرر إجراؤه في البرازيل وجنوب إفريقيا والمملكة المتحدة، سيتم تعليقه مؤقتًا". ويشار إلى أن البوابة العلمية الأمريكية "STAT" ذكرت، يوم أمس الثلاثاء، أنه تم تعليق التجارب السريرية للقاح، الذي طوره متخصصون من...
مقال مؤرشفهذا المقال مخصص للمشتركين
انضموا إلينا للوصول إلى هذا المقال وجميع المحتويات، لا تفوتوا المعلومات التي تهمكم.
لديك حساب ؟ تسجيل الدخول

التعليقات
شارك تسجيل الدخول
الخروج
التعليقات مغلقة لهذا المقال